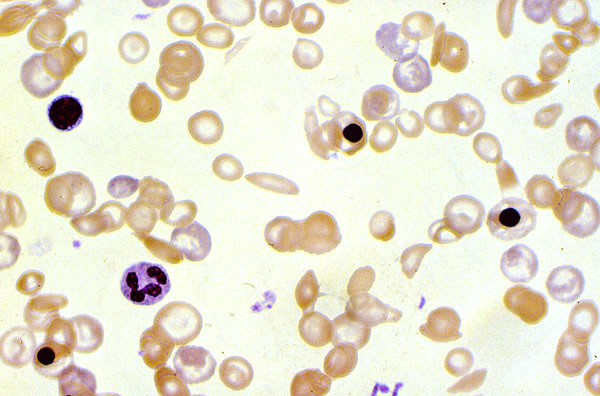

Sickle cell anemia, peripheral blood smear
Click picture to enlarge. Close window to return
The red cells show anisopoikilocytosis. several nucleated red blood cells are present, which reflect an appropriate response to maintain the RBC count in the situation of increased RBC destruction due to hemolysis of sicle cells.